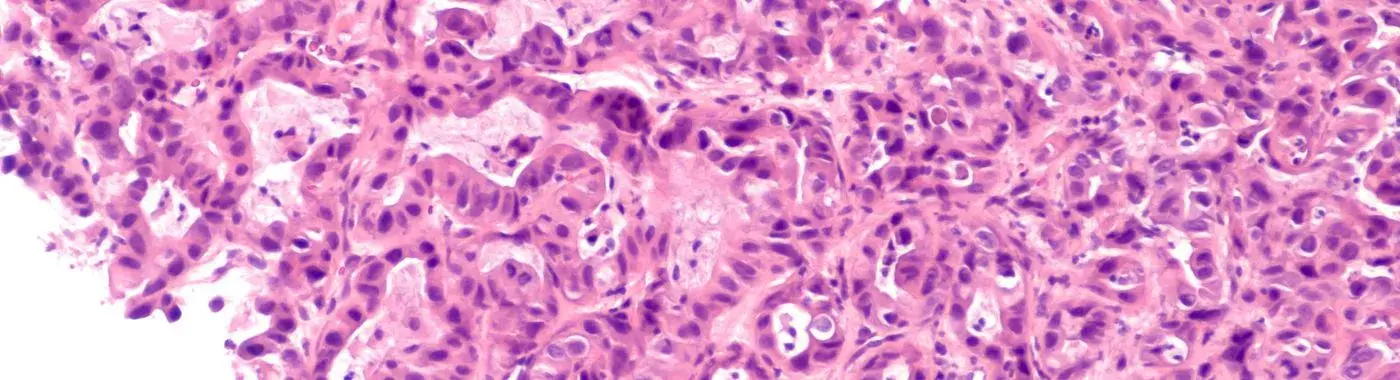
Whipple's Disease - Causes, Symptoms, Diagnosis, Treatment, and Prevention

- Diseases and Conditions
- Whipple's Disease - Causes, Symptoms, Diagnosis, Treatment, and Prevention
Whipple's Disease - Causes, Symptoms, Diagnosis, Treatment, and Prevention
Whipple's Disease: A Comprehensive Guide
Introduction
Whipple's Disease is a rare but serious condition that primarily affects the gastrointestinal system, leading to a range of symptoms that can significantly impact a person's health and quality of life. Named after Dr. George Whipple, who first described the disease in 1907, it is caused by the bacterium Tropheryma whipplei. Understanding Whipple's Disease is crucial for early diagnosis and effective treatment, as it can lead to severe complications if left untreated. This article aims to provide a comprehensive overview of Whipple's Disease, including its causes, symptoms, diagnosis, treatment options, and more.
Definition
What is Whipple's Disease?
Whipple's Disease is a systemic illness characterized by the malabsorption of nutrients due to the infiltration of the intestinal wall by the bacterium Tropheryma whipplei. This condition can affect various organs, including the heart, brain, and joints, leading to a wide array of symptoms. Although it is rare, with an estimated incidence of 1 in 1 million people, its potential severity makes it a significant health concern.
Causes and Risk Factors
Infectious/Environmental Causes
Whipple's Disease is primarily caused by the bacterium Tropheryma whipplei, which is believed to be present in the environment, particularly in soil and water. The exact mode of transmission is not fully understood, but it is thought that the bacterium may enter the body through the gastrointestinal tract.
Genetic/Autoimmune Causes
There is evidence to suggest that genetic predisposition may play a role in the development of Whipple's Disease. Some studies indicate that individuals with certain genetic markers, particularly those related to the immune system, may be more susceptible to the disease. Additionally, it has been suggested that an autoimmune component may contribute to the disease's progression, as the immune response to the bacterium can lead to inflammation and damage to the intestinal lining.
Lifestyle and Dietary Factors
While the direct link between lifestyle and Whipple's Disease is not well established, certain dietary habits and lifestyle choices may influence the risk of developing the condition. For instance, individuals with a history of malabsorption syndromes or those who consume a diet low in fiber may be at a higher risk.
Key Risk Factors
- Age: Whipple's Disease is most commonly diagnosed in middle-aged men, typically between the ages of 40 and 60.
- Gender: Males are more frequently affected than females, with a male-to-female ratio of approximately 6:1.
- Geographic Location: The disease is more prevalent in certain regions, particularly in Europe and North America, although it can occur worldwide.
- Underlying Conditions: Individuals with compromised immune systems, such as those with HIV/AIDS or other immunodeficiencies, may be at increased risk.
Symptoms
Whipple's Disease presents a variety of symptoms, which can vary widely among individuals. Common symptoms include:
- Diarrhea: Often chronic and may be accompanied by weight loss.
- Abdominal Pain: Cramping or discomfort in the abdomen.
- Fatigue: Persistent tiredness that does not improve with rest.
- Weight Loss: Unintentional weight loss due to malabsorption of nutrients.
- Joint Pain: Arthritis-like symptoms affecting the joints.
- Fever: Low-grade fever may occur in some cases.
- Nutritional Deficiencies: Symptoms related to deficiencies in vitamins and minerals, such as anemia or osteoporosis.
Warning Signs
Certain symptoms may indicate the need for immediate medical attention, including:
- Severe abdominal pain that does not improve.
- Persistent high fever.
- Signs of dehydration, such as extreme thirst, dry mouth, or dizziness.
- Sudden changes in mental status, such as confusion or disorientation.
Diagnosis
Clinical Evaluation
The diagnosis of Whipple's Disease begins with a thorough clinical evaluation, including a detailed patient history and physical examination. Physicians will inquire about symptoms, dietary habits, and any underlying health conditions.
Diagnostic Tests
Several diagnostic tests may be employed to confirm the presence of Whipple's Disease:
- Laboratory Tests: Blood tests may reveal anemia, low protein levels, and other signs of malabsorption.
- Imaging Studies: X-rays, CT scans, or MRI may be used to assess the extent of organ involvement.
- Endoscopy and Biopsy: An upper endoscopy may be performed to obtain tissue samples from the small intestine, which can be examined for the presence of Tropheryma whipplei.
Differential Diagnosis
It is essential to differentiate Whipple's Disease from other conditions that may present similar symptoms, such as Crohn's disease, celiac disease, and other malabsorption syndromes. A thorough evaluation and appropriate testing are crucial for accurate diagnosis.
Treatment Options
Medical Treatments
The primary treatment for Whipple's Disease involves the use of antibiotics. The standard regimen typically includes:
- Initial Antibiotic Therapy: A combination of intravenous antibiotics, such as ceftriaxone or penicillin, is often administered for a period of 2 to 4 weeks.
- Oral Antibiotics: Following the initial treatment, patients may be prescribed oral antibiotics, such as sulfamethoxazole-trimethoprim, for an extended period (usually 1 to 2 years) to prevent relapse.
Non-Pharmacological Treatments
In addition to antibiotic therapy, certain lifestyle modifications and dietary changes can help manage symptoms and improve overall health:
- Dietary Changes: A well-balanced diet rich in nutrients can help address deficiencies and improve absorption. Consulting with a nutritionist may be beneficial.
- Hydration: Maintaining adequate fluid intake is essential, especially for those experiencing diarrhea.
- Alternative Therapies: Some patients may explore complementary therapies, such as probiotics or herbal supplements, although these should be discussed with a healthcare provider.
Special Considerations
- Pediatric Population: Whipple's Disease is rare in children, but treatment protocols are similar to those for adults. Pediatric patients may require careful monitoring for growth and development.
- Geriatric Population: Older adults may have different responses to treatment and may require adjustments in medication dosages.
Complications
If left untreated or poorly managed, Whipple's Disease can lead to several complications, including:
- Nutritional Deficiencies: Prolonged malabsorption can result in severe deficiencies, leading to conditions such as anemia, osteoporosis, and neurological issues.
- Organ Damage: The disease can affect various organs, leading to complications such as heart disease, neurological disorders, and joint damage.
- Recurrence: Even after successful treatment, there is a risk of relapse, necessitating ongoing monitoring and management.
Short-Term and Long-Term Complications
Short-term complications may include severe dehydration and electrolyte imbalances due to diarrhea. Long-term complications can involve chronic health issues related to nutritional deficiencies and organ damage.
Prevention
While there is no guaranteed way to prevent Whipple's Disease, certain strategies may help reduce the risk:
- Hygiene Practices: Good hygiene, including proper handwashing and food safety practices, can help minimize exposure to potential infectious agents.
- Dietary Modifications: A balanced diet rich in fiber and nutrients may support overall gut health.
- Regular Health Check-ups: Routine medical evaluations can help identify any underlying health issues early on.
Prognosis & Long-Term Outlook
The prognosis for individuals diagnosed with Whipple's Disease largely depends on the timeliness of diagnosis and treatment. With appropriate antibiotic therapy, many patients can achieve significant improvement and may even experience complete resolution of symptoms. However, some individuals may require long-term management to address ongoing health issues.
Factors influencing the overall prognosis include:
- Early Diagnosis: Prompt identification and treatment of the disease can lead to better outcomes.
- Adherence to Treatment: Following the prescribed treatment regimen is crucial for preventing relapse and managing symptoms effectively.
Frequently Asked Questions (FAQs)
- What are the early symptoms of Whipple's Disease? Early symptoms may include persistent diarrhea, abdominal pain, fatigue, and unintentional weight loss. If you experience these symptoms, consult a healthcare provider for evaluation.
- How is Whipple's Disease diagnosed? Diagnosis typically involves a combination of clinical evaluation, laboratory tests, imaging studies, and tissue biopsy to confirm the presence of Tropheryma whipplei.
- What is the treatment for Whipple's Disease? Treatment primarily involves a course of antibiotics, starting with intravenous medications followed by oral antibiotics for an extended period to prevent relapse.
- Can Whipple's Disease be cured? With appropriate treatment, many patients can achieve significant improvement, and some may experience complete resolution of symptoms. However, ongoing monitoring is essential.
- What complications can arise from untreated Whipple's Disease? Untreated Whipple's Disease can lead to severe nutritional deficiencies, organ damage, and chronic health issues, making early diagnosis and treatment crucial.
- Is Whipple's Disease contagious? No, Whipple's Disease is not contagious. It is caused by a bacterium that is believed to be present in the environment.
- Are there any lifestyle changes that can help manage Whipple's Disease? Yes, dietary modifications, maintaining hydration, and regular medical check-ups can help manage symptoms and improve overall health.
- How long does treatment for Whipple's Disease last? Initial treatment with intravenous antibiotics typically lasts 2 to 4 weeks, followed by oral antibiotics for 1 to 2 years to prevent relapse.
- What should I do if I experience symptoms of Whipple's Disease? If you experience symptoms such as persistent diarrhea, abdominal pain, or unexplained weight loss, seek medical attention promptly for evaluation and diagnosis.
- Can Whipple's Disease affect children? While rare, Whipple's Disease can occur in children. Treatment protocols are similar to those for adults, and careful monitoring is essential.
When to See a Doctor
Seek immediate medical attention if you experience any of the following serious symptoms:
- Severe abdominal pain that does not improve.
- Persistent high fever.
- Signs of dehydration, such as extreme thirst, dry mouth, or dizziness.
- Sudden changes in mental status, such as confusion or disorientation.
Conclusion & Disclaimer
Whipple's Disease is a rare but serious condition that requires prompt diagnosis and treatment to prevent complications. Understanding its causes, symptoms, and treatment options is essential for effective management. If you suspect you may have Whipple's Disease or are experiencing related symptoms, consult a healthcare professional for evaluation and guidance.
Disclaimer: This article is for informational purposes only and does not replace professional medical advice. Always consult a healthcare provider for medical concerns or questions regarding your health.


 Best Hospital Near me Chennai
Best Hospital Near me Chennai

